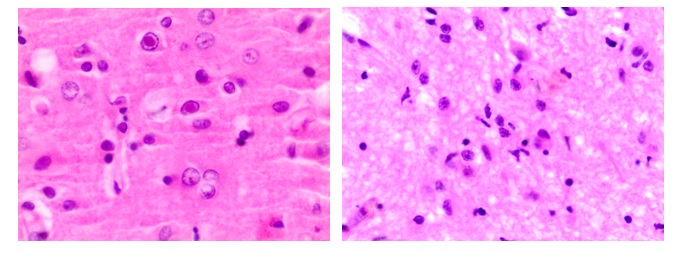
infographic

Wyszukaj egzamin lub pytanie
Egzamin PES Neurologia / wiosna 2017
120 pytań
Pytanie 1
W leczeniu rzutu SM podaje się dożylnie metyloprednizolon. Typowe postępowanie polega na podawaniu:
Pytanie 2
Wskaż fałszywe stwierdzenie dotyczące leczenia SM mitoksantronem:
1) znalazł zastosowanie w leczeniu pierwotnie postępującej postaci choroby;
2) skumulowana dawka życiowa wynosi 140 mg/m²;
3) powikłaniem leczenia może być kardiomiopatia;
4) lek może powodować zahamowanie czynności szpiku, łysienie i nudności;
5) u około 3% chorych może dojść do rozwoju białaczki.
Prawidłowa odpowiedź to:
Pytanie 3
Wskaż prawdziwe stwierdzenia dotyczące leczenia stwardnienia rozsianego:
1) natalizumab podaje się w dawce 100 mg/dobę raz na cztery tygodnie;
2) przeciwciała neutralizujące powstają u 25-40% chorych leczonych interferonem beta 1b;
3) w ostrym rzucie choroby przy nieskuteczności steroidów stosuje się plazmaferezę;
4) najczęstszymi działaniami niepożądanymi octanu glatirameru są reakcje w miejscu wstrzyknięcia;
5) PML (postępująca wieloogniskowa leukoencefalopatia) może wystąpić po podawaniu natalizumabu.
Prawidłowa odpowiedź to:
Pytanie 4
Który z poniżej podanych czynników rokowniczych w stwardnieniu rozsianym jest korzystny pod względem prognostycznym?
Pytanie 5
Wśród następujących jednostek chorobowych wymień te, które wymagają różnicowania ze stwardnieniem rozsianym:
1) sarkoidoza;
2) choroba Behçeta;
3) toczeń układowy;
4) neuro-AIDS;
5) neuroborelioza.
Prawidłowa odpowiedź to:
Pytanie 6
Wskaż fałszywe stwierdzenie dotyczące ognisk T2 w obrębie rdzenia kręgowego w stwardnieniu rozsianym:
Pytanie 7
U pacjenta alkoholika wystąpiły: postępujący zespół otępienny, wieloogniskowe objawy neurologiczne oraz drgawki. W badaniu NMR stwierdzono zmiany w ciele modzelowatym oraz symetryczne ogniska demielinizacji w podkorowej istocie białej. W obrazie sekcyjnym stwierdzono martwicę środkowej części ciała modzelowatego i spoidła przedniego z zaoszczędzeniem części brzeżnych. Powyższy obraz wskazuje na:
Pytanie 8
Wskaż prawdziwe stwierdzenia dotyczące SM:
1) najczęściej choroba ma przebieg rzutowo-remisyjny;
2) postać pierwotnie przewlekle postępująca występuje u około 5% pacjentów;
3) w połogu dochodzi do zwiększenia ryzyka rzutu choroby;
4) zaburzenia funkcji poznawczych występują u około 10% chorych;
5) szczepienia przeciwko wirusowi grypy nie zwiększają ryzyka rzutu choroby.
Prawidłowa odpowiedź to:
Pytanie 9
Wskaż prawdziwe stwierdzenia dotyczące SM:
1) w patogenezę SM zaangażowane są między innymi limfocyty Th 17;
2) reakcja immunologiczna jest poliklonalna i skierowana przeciwko kilku antygenom;
3) limfocyty B biorą udział w immunopatogenezie choroby;
4) ogniska demielinizacji wykrywane są często w istocie białej okołokomorowej;
5) w przebiegu choroby dochodzi do uszkodzenia aksonów.
Prawidłowa odpowiedź to:
Pytanie 10
Wskaż fałszywe stwierdzenia dotyczące SM:
1) choroba dotyka około 2,5 miliona osób na świecie;
2) choroba zwykle rozpoczyna się w wieku 20-40 lat;
3) podwyższone ryzyko zachorowania obserwuje się u rasy białej;
4) kobiety chorują trzykrotnie częściej niż mężczyźni;
5) zgodność zachorowania u bliźniąt jednojajowych wynosi 5%.
Prawidłowa odpowiedź to:
Pytanie 11
Około 70 % wewnątrzrdzeniowych naczyniaków krwionośnych zarodkowych (hemangioblastoma) występuje sporadycznie, natomiast około 30 % jest związanych z następującym zespołem chorobowym:

Pytanie 12
Obecność w mózgu alfa-synukleiny, białka o patologicznej strukturze, obserwuje się w:
Pytanie 13
W gwiaździaku anaplastycznym (astrocytoma anaplasticum) III stopień wg. WHO, o złośliwości guza decydują następujące cechy, z wyjątkiem:
Pytanie 14
W gwiaździaku rozlanym (diffuse astrocytoma), większość komórek nowotworowych, a zwłaszcza ich wypustek, wykazuje wyraźną ekspresję jednego z wymienionych przeciwciał:
Pytanie 15
W badaniu mikroskopowym mózgu, charakterystyczne dla zwyrodnienia mózgu z gromadzeniem żelaza (NBIA, neurodegeneration with brain iron accumulation), poza gromadzeniem żelaza, obecne są liczne sferoidy (okrągłe/owalne twory będące odcinkowym obrzękniętym aksonem), które występują w wymienionych strukturach, z wyjątkiem:
Pytanie 16
W mózgach osób chorych na zwyrodnienie wątrobowo-soczewkowe (choroba Wilsona), pojawiają się patologiczne formy astrogleju. Jedną z nich nazywa się:

Pytanie 17
Ciała Picka, występujące w zwyrodnieniu płatów czołowych i skroniowych (FTLD) z ciałami Picka, w badaniu immunohistochemicznym wykazują pozytywną reakcję z:
Pytanie 18
W jakim typie zapalenia w badaniu neuropatologicznym mózgu dominują nacieki limfocytarno-mikroglejowe oraz wtręty śródjądrowe?
Pytanie 19
Zwyrodnienie neurowłókienkowe (neurofibrylarne), widoczne jest w mózgu podczas badania neuropatologicznego w następujących chorobach, z wyjątkiem:

Pytanie 20
Neuroferrytynopatia to:
Pytanie 21
Mózgowa angiopatia amyloidowa (CAA, cerebral amyloid angiopathy), nie bierze udziału w patogenezie:

Pytanie 22
W zwyrodnieniu mózgu związanym z hydrolazą kwasów tłuszczowych (zespół FAHN - fatty acid hydrolase-associated neurodegeneration) w badaniu rezonansu magnetycznego stwierdza się typowo:
Pytanie 23
W leczeniu dystonii w chorobie Huntingtona stosuje się:
Pytanie 24
Spastyczna paraplegia o dziedziczeniu sprzężonym z chromosomem X typu 1 (SPG1) jest spowodowana mutacjami w genie:
Pytanie 25
Wskaż prawdziwe stwierdzenie dotyczące mioklonii podniebienia:
Pytanie 26
Wskaż zasady leczenia gruźlicy ośrodkowego układu nerwowego:
1) na początku podaje się 4 leki przeciwprątkowe (INH, RMP, PZA, EMB);
2) okres całkowity leczenia trwa 12 miesięcy;
3) w drugiej fazie - powyżej 3 miesięcy stosuje się RMP i INH;
4) nie stosuje się pirydoksyny;
5) nie podaje się steroidów.
Prawidłowa odpowiedź to:
Pytanie 27
Odczyn VDRL:
1) jest ujemny w kile bezobjawowej;
2) jest zawsze dodatni w porażeniu postępującym;
3) w 50-85% jest dodatni w wiądzie rdzenia;
4) pozwala na rozpoznanie pewne kiły układu nerwowego;
5) nie ma znaczenia w diagnostyce kiły.
Prawidłowa odpowiedź to:
Pytanie 28
Chemioprofilaktyka zakażeń wywołanych przez Neisseria meningitidis polega na podawaniu jednego z antybiotyków osobie z bliskiego otoczenia chorego. Wskaż zalecane schematy:
1) ryfampicyna doustnie przez 7 dni;
2) ceftriakson doustnie jednorazowo;
3) cyprofloksacyna doustnie jednorazowo;
4) cyprofloksacyna doustnie przez tydzień;
5) ryfampicyna przez 2 dni.
Prawidłowa odpowiedź to:
Pytanie 29
W niedoborze kwaśnej maltazy spowodowanej mutacjami w genie GAA na chromosomie 17 (choroba Pompego) z początkiem w wieku dorosłym:
1) struktura spichrzanego glikogenu jest prawidłowa;
2) często występują zmiany morfologiczne w OUN;
3) defekt enzymatyczny prowadzi do patologicznego poszerzania się naczyń i tworzenia tętniaków;
4) w części przypadków stwierdza się objawy neuropatii obwodowej;
5) często występuje miopatia z przewagą zajęcia mięśni proksymalnych;
6) często występuje miopatia z przewagą zajęcia mięśni dystalnych.
Prawidłowa odpowiedź to:
Pytanie 30
Dla encefalopatii mitochondrialnej z kwasicą mleczanową i epizodami przypominającymi udar mózgu (MELAS) charakterystyczne są:
1) występowanie objawów przed 40. r.ż.;
2) niedowidzenie połowiczne jednoimienne;
3) ślepota korowa;
4) uogólnione napady drgawkowe;
5) nawracające migrenopodobne bóle głowy;
6) obecność włókien szmatowatych (Ragged Red Fibers - RRFs) w biopsji mięśnia.
Prawidłowa odpowiedź to:
Pytanie 31
Wskaż prawdziwe stwierdzenie dotyczące dziedzicznej neuropatii nerwu wzrokowego Lebera:
1) częściej występuje u kobiet;
2) rozpoczyna się zwykle w okresie dojrzewania;
3) pogorszenie widzenia centralnego następuje w ciągu kilku tygodni;
4) pogorszenie widzenia centralnego występuje nagle;
5) objawem poprzedzającym pogorszenie widzenia jest ból;
6) proces przeważnie dotyczy obu oczu.
Prawidłowa odpowiedź to:
Pytanie 32
Do cech wspólnych dystrofii miotonicznej typu 2 i miotonii wrodzonej typu Beckera należą
1) dziedziczenie autosomalne dominujące;
2) dziedziczenie autosomalne recesywne;
3) obecność objawów klinicznych miotonii;
4) zaćma;
5) obecność ciągów miotonicznych w zapisie EMG;
6) przerost mięśni.
Prawidłowa odpowiedź to:
Pytanie 33
Choroba Kennedy`ego (zanik mięśni rdzeniowo-opuszkowy) charakteryzuje się wszystkimi wymienionymi cechami, z wyjątkiem:
Pytanie 34
Do dystrofii mięśniowych sprzężonych z chromosomem X należy:
Pytanie 35
Wskaż prawdziwe stwierdzenia dotyczące zespołu Guillaina-Barrègo:
1) objawy postępują przez okres 8 tygodni;
2) objawy są zwykle asymetryczne;
3) skuteczne jest leczenie kortykosteroidami zastosowane w ciągu pierwszych 2 tygodni trwania choroby.
Prawidłowa odpowiedź to:
Pytanie 36
Do charakterystycznych cech klinicznych zespołu miastenicznego Lamberta-Eatona należą wszystkie wymienione, z wyjątkiem:
Pytanie 37
U 30-letniej kobiety stwierdzono narastający od kilku tygodni niedowład kończyn górnych i dolnych nasilony w odcinkach ksobnych oraz zaburzenia połykania. W badaniach diagnostycznych prawdopodobnie stwierdzi się:
1) wysoki poziom kinazy kreatyny (CK) w surowicy;
2) podwyższony poziom przeciwciał przeciwko receptorom acetylocholiny (AchR-Ab) w surowicy;
3) zapis miogenny w elektromiografii;
4) obecność fibrylacji i dodatnich fal wkłucia w zapisie EMG;
5) obecność fascykulacji w zapisie EMG;
6) dodatni wynik elektrostymulacyjnej próby męczliwości.
Prawidłowa odpowiedź to:
Pytanie 38
W każdym przypadku krótkotrwałych zaburzeń świadomości ocena wstępna powinna zawierać niżej wymienione, z wyjątkiem:
Pytanie 39
Czynnikami usposabiającymi do wystąpienia napadu padaczkowego mogą być niżej wymienione, z wyjątkiem:
Pytanie 40
Do pozagenetycznych czynników wpływających na wystąpienie padaczki należą niżej wymienione, z wyjątkiem:
Pytanie 41
Wskaż co nie należy do cech charakterystycznych napadu toniczno-klonicznego:
Pytanie 42
Wskaż co nie należy do cech charakterystycznych typowych napadów nieświadomości:
Pytanie 43
Wskaż co nie należy do obrazu łagodnych, rodzinnych drgawek noworodków:
Pytanie 44
Do leków przeciwpadaczkowych mogących nasilać mioklonie, nie należy:
Pytanie 45
Wskaż fałszywe stwierdzenie dotyczące padaczki światłoczułej:
Pytanie 46
Wskaż fałszywe stwierdzenie dotyczące EEG u osoby chorej na padaczkę:
Pytanie 47
Wskaż prawdziwe stwierdzenia dotyczące padaczki z napadami nieświadomości wieku dziecięcego:
1) początek najczęściej między 4-10 r.ż.;
2) napady zwykle rozpoczynają się tuż po urodzeniu;
3) typowy zapis w EEG to uogólniona czynność iglica-fala wolna (3 Hz);
4) typowy zapis w EEG to uogólniona czynność iglica-fala wolna (12 Hz);
5) zespół cechuje postępujący regres funkcji poznawczych;
6) rokowanie w większości przypadków dobre.
Prawidłowa odpowiedź to:
Pytanie 48
Wskaż prawdziwe stwierdzenia dotyczące zespołu Lennoxa-Gastauta:
1) rozpoczyna się w okresie młodzieńczym;
2) pierwsze objawy występują w wieku niemowlęcym;
3) jest to zespół polietiologiczny;
4) w większości są to zespoły uwarunkowane genetycznie;
5) występuje opóźnienie rozwoju umysłowego i lekooporność;
6) cechuje się dobrym rokowaniem i szybką odpowiedzią na leczenie.
Prawidłowa odpowiedź to:
Pytanie 49
U pacjenta w wieku 15 lat, dotychczas zdrowego, w ostatnim czasie pojawiły się epizody zrywania w zakresie kończyn górnych, zwykle po przebudzeniu (często przy śniadaniu przewraca naczynia). Dodatkowo występują napady toniczne-kloniczno uogólnione w ciągu dnia. Rozwój umysłowy prawidłowy. Pacjent jest jedynakiem a w rodzinie nie było przypadków padaczki. Wskaż najbardziej prawdopodobne rozpoznanie:
Pytanie 50
Padaczkę lekooporną rozpoznaje się, gdy:
Pytanie 51
Leki przeciwpadaczkowe, które mają wpływ na działanie leków antykoncepcyjnych to:
1) karbamazepina;
2) gabapentyna;
3) fenobarbital;
4) lewetyracetam;
5) fenytoina.
Prawidłowa odpowiedź to:
Pytanie 52
Zespół nagłej, niewytłumaczonej śmierci w padaczce (SUDEP):
1) występuje u osób z padaczką z podobną częstością jak w populacji ogólnej;
2) występuje 25-krotnie częściej u osób z padaczką niż w populacji ogólnej;
3) obejmuje przypadki osób, u których stwierdzono współistniejącą chorobę serca;
4) obejmuje częściej przypadki młodych mężczyzn (20-40 lat);
5) czynnikiem ryzyka są niekontrolowane napady padaczkowe uogólnione;
6) czynnikiem ryzyka są urazy głowy związane z napadami padaczkowymi.
Prawidłowa odpowiedź to:
Pytanie 53
W leczeniu napadu klasterowego bólu głowy najskuteczniejsze jest podanie:
Pytanie 54
Pacjent praworęczny od około 10. roku życia podaje epizody zaburzeń świadomości, poprzedzone często bólami brzucha. Pacjent nieruchomieje patrząc w dal a następnie wykonuje ruchy rękoma rozpinając i zapinając guziki koszuli. Często występują również napady uogólnione toniczno-kliniczne. W MRI obecna znaczna asymetria w zakresie struktur przyśrodkowych płatów skroniowych z cechami atrofii i podwyższonym sygnałem po stronie prawej. Leczenie farmakologiczne przyniosło tylko częściową poprawę. W dzieciństwie rodzice obserwowali drgawki gorączkowe. Postępowaniem z wyboru dla tego pacjenta jest kwalifikacja do:
Pytanie 55
Lek przeciwpadaczkowy, który nie jest metabolizowany przez wątrobę to:
Pytanie 56
Do rozszerzenia naczyń mózgowych w napadzie migreny dochodzi w następstwie intensywnego uwalniania z zakończeń nerwowych:
Pytanie 57
W klasterowym bólu głowy nie występuje:
Pytanie 58
W neuralgii trójdzielnej nie obserwuje się:
Pytanie 59
Do zajęcia tkanki mózgowej może dość w przypadku oponiaka:
Pytanie 60
Na symptomatologię kliniczną oponiaków kąta mostowo-móżdżkowego składa się:
Pytanie 61
Do nowotworów z pierwotnych komórek zarodkowych zalicza się:
Pytanie 62
W zespole Parinauda nie występuje:
Pytanie 63
Głęboka stymulacja mózgu u chorego z dystonią powinna dotyczyć:
Pytanie 64
Lekiem z wyboru w leczeniu drżenia samoistnego jest:
Pytanie 65
W leczeniu pląsawicy Huntingtona lekiem z wyboru jest:
Pytanie 66
Wskaż cechę typową dla choroby tików:
Pytanie 67
Obraz „wypalonego krzyża” w rezonansie magnetycznym mózgu jest typowy dla:
Pytanie 68
U chorego z prawdopodobnym wodogłowiem normotensyjnym największe znaczenie prognostyczne dla dalszego postępowania ma:
Pytanie 69
Badanie DaTSCAN (transportera dopaminy):
Pytanie 70
U 64-letniego chorego z postępującym od pół roku spowolnieniem ruchowym lewej kończyny górnej rozpoznano chorobę Parkinsona. Badanie neuropsychologiczne ujawniło zaburzenia pamięci. Rozpoczęto leczenie lewodopą w dawce 3 x 100 mg uzyskując poprawę stanu ruchowego. W ciągu dwu tygodni pojawiły się halucynacje. Najbardziej prawdopodobne rozpoznanie to:
Pytanie 71
Wskaż prawdziwe stwierdzenie dotyczące zespołu korowo-podstawnego:
Pytanie 72
Wskaż prawdziwe stwierdzenie dotyczące zaniku wieloukładowego:
Pytanie 73
Które z poniższych stwierdzeń jest fałszywe?
Pytanie 74
Wskaż fałszywe stwierdzenia dotyczące krwotoku podpajęczynówkowego:
1) chorzy po przebytym krwotoku podpajęczynówkowym, u których tętniaka zaopatrzono neurochirurgicznie przy pomocy klipsowania lub obliteracji wewnątrznaczyniowej mają podobne ryzyko wystąpienia kolejnego krwotoku podpajęczynówkowego, jak populacja bez krwotoku w wywiadzie;
2) ryzyko krwotoku podpajęczynówkowego u pacjenta zwiększa się, jeżeli taki krwotok wystąpił poprzednio u jego krewnego pierwszego stopnia;
3) chorzy z wielotorbielowatością nerek wykazują zwiększoną zapadalność na tętniaki workowate naczyń mózgowych;
4) na obecnym poziomie wiedzy możliwe jest już określenie jednoznacznych genów ryzyka w rodzinach z dodatnim wywiadem odnośnie krwotoków podpajęczynówkowych;
5) zespół Ehlersa-Danlosa jest czynnikiem ryzyka wystąpienia tętniaka.
Prawidłowa odpowiedź to:
Pytanie 75
Wskaż prawdziwe kryteria i zalecenia dotyczące leczenia trombolitycznego w ostrym udarze niedokrwiennym mózgu:
1) leczenie można włączyć gdy czas trwania objawów wynosi co najmniej 30 minut bez znaczącej poprawy przed leczeniem;
2) leczenie można włączyć gdy czas trwania objawów wynosi co najmniej 60 minut bez znaczącej poprawy przed leczeniem;
3) ciśnienie tętnicze krwi w chwili przyjęcia do szpitala nie może przekraczać skurczowe: > 185 mmHg i rozkurczowe: > 110 mmHg;
4) u chorych z nietrzymaniem moczu konieczne jest założenie cewnika Foleya do pęcherza moczowego przed rozpoczęciem leczenia trombolitycznego;
5) ciśnienie tętnicze krwi w chwili rozpoczęcia leczenia trombolitycznego nie może przekraczać skurczowe: > 185 mmHg i rozkurczowe: > 110 mmHg.
Prawidłowa odpowiedź to:
Pytanie 76
Pacjent lat 75 został przyjęty do Szpitalnego Oddziału Ratunkowego z powodu izolowanego niedowładu połowiczego prawostronnego z objawem Rossolimo. Poza tym nie stwierdzano innych objawów w badaniu neurologicznym, chory przytomny, logiczny. RR przy przyjęciu 155/100 mmHg, stężenie glukozy 130 mg/dl. W wywiadzie cukrzyca typu 2, innych schorzeń nie podaje. Najbardziej prawdopodobną przyczyną wyżej wymienionych objawów ze strony układu nerwowego jest:
Pytanie 77
Wskaż prawdziwe stwierdzenie dotyczące leczenia złośliwego obrzęku mózgu w przebiegu udaru niedokrwiennego:
Pytanie 78
U 75-letniego chorego z epizodem niedowładu połowiczego prawostronnego trwającym około 15 minut rozpoznano przemijające niedokrwienie mózgu (TIA). W badaniu Holter-EKG stwierdzono dwa epizody pięciosekundowego migotania przedsionków. Badanie ECHO serca nie wykazało wady zastawkowej, badanie internistyczne nie wykazało odchyleń poza nadciśnieniem tętniczym. U tego chorego w leczeniu profilaktycznym należy:
Pytanie 79
Wskaż prawdziwe stwierdzenia dotyczące krwotoku mózgowego:
1) lokalizacja w strukturach głębokich wskazuje na wyższe prawdopodobieństwo choroby małych naczyń jako przyczyny krwotoku;
2) lokalizacja w strukturach głębokich wskazuje na wyższe prawdopodobieństwo angiopatii amyloidowej jako przyczyny krwotoku;
3) w badaniu tomografii komputerowej zmiana jest hyperdensyjna w pierwszych 7 dniach od udaru, po około 7 dniach zmiana staje się izodensyjna, a po około miesiącu hipodensyjna;
4) badanie tomografii rezonansu magnetycznego (MRI) nie jest przydatne w obrazowaniu ostrej fazy krwotoków mózgowych, gdyż nie istnieją sekwencje MRI pozwalające uwidocznić ognisko krwotoczne;
5) nieproporcjonalnie duży obrzęk mózgu w stosunku do wynaczynionej krwi może sugerować ukrwotocznienie w przebiegu guza mózgu;
6) leczeniem z wyboru w krwiaku o lokalizacji płatowej jest leczenie operacyjne, które trzeba przeprowadzić w trybie pilnym.
Prawidłowa odpowiedź to:
Pytanie 80
Nie jest prawdą, że w ostrej fazie udaru niedokrwiennego mózgu:
Pytanie 81
Wskaż prawdziwe stwierdzenie dotyczące zakrzepicy żylnej mózgu:
Pytanie 82
Wskaż prawdziwe stwierdzenia dotyczące rehabilitacji po udarze mózgu:
1) w przypadku zespołu bolesnego barku po udarze, najlepsze wyniki uzyskuje się dzięki ćwiczeniom w systemie ciężarkowo-bloczkowym;
2) chorzy z porażeniem połowiczym oraz z prawidłowym testem połykania mogą być karmieni w pozycji siedzącej lub leżącej, zależnie od preferencji chorego;
3) chorzy z zaburzeniami połykania ale bez zaburzeń afatycznych wymagają opieki neurologopedycznej;
4) w przypadku chorych w stanie ciężkim, z punktacją skali NIHSS (National Institutes of Health Stroke Scale) ponad 25 punktów, postępowanie rehabilitacyjne powinno być podjęte nie wcześniej niż po 7 dniach od udaru;
5) u pacjenta z niedowładem nie należy stosować szyn i łusek w celu poprawy funkcji ruchowych niedowładnej kończyny górnej;
6) u chorych leżących założenie cewnika do pęcherza moczowego nie powinno być procedurą rutynową.
Prawidłowa odpowiedź to:
Pytanie 83
Zespół postępującej ataksji z drżeniem podniebienia (PAPT), będący odmianą mioklonii podkorowej, charakteryzuje się:
Pytanie 84
W hiperekpleksji rodzinnej (startle syndrome) - jednej z mioklonii podkorowych - objawy:
Pytanie 85
Powikłaniami spastycznych paraplegii rodzinnych są:
1) dyzartria, neuropatia obwodowa z zaburzeniem czucia proprioceptywnego i łagodne zaburzenia poznawcze;
2) ataksja, zaburzenia widzenia o charakterze kwadrantowego ograniczenia pola widzenia i napady padaczkowe;
3) ataksja, łagodne zaburzenia poznawcze i zanik mięśni;
4) napady padaczkowe, zaburzenia widzenia o charakterze niedowidzenia połowiczego dwuskoroniowego, i neuropatia obwodowa z zaburzeniem czucia proprioceptywnego.
Prawidłowa odpowiedź to:
Pytanie 86
W zwyrodnieniu mózgu związanym z kinazą pantotenową (PKAN):
1) w postaci klasycznej choroba rozwija się od okresu wczesnej młodości a pierwszymi objawami są zaburzenia chodu i postawy;
2) charakterystycznym objawem w badaniu neuroobrazowym jest hiperintensywny obszar otoczony strefą o obniżonej intensywności sygnału w głowie jądra ogoniastego;
3) choroba związana jest etiopatogenetycznie z mutacjami w genie PANK2, kodującym kinazę pantotenową 2;
4) w postaci atypowej objawy pojawiają się we wczesnej młodości, z gwałtownym przebiegiem objawów piramidowych i pozapiramidowych;
5) w postaci atypowej szybko postępuje zanik nerwu wzrokowego.
Prawidłowa odpowiedź to:
Pytanie 87
W dystonii mioklonicznej (DYT 11) na tle wyładowań mioklonicznych w mięśniach:
Pytanie 88
W spastycznych paraplegiach:
Pytanie 89
Neuropatie jamajskie (spastyczna paraplegia tropikalna, ataktyczna neuropatia tropikalna) w swoim profilu patologicznym cechują się:
Pytanie 90
Wariant młodzieńczy pierwotnego stwardnienia bocznego (PLS) w swoim profilu kliniczno-patologicznym charakteryzuje się:
Pytanie 91
W badaniu neurologicznym w spastycznych paraplegiach rodzinnych najczęściej występuje:
Pytanie 92
Zaćma słonecznikowa jest objawem charakterystycznym dla:
Pytanie 93
Aura nie jest swoistą cechą migreny. Typowa aura migrenowa może wystąpić w przebiegu innego bólu głowy, np.:
Pytanie 94
Wskaż fałszywe stwierdzenie dotyczące pierwotnego chłoniaka ośrodkowego układu nerwowego:
Pytanie 95
W leczeniu wieloogniskowej neuropatii ruchowej stosuje się:
Pytanie 96
Nowotworami charakterystycznymi dla stwardnienia guzowatego są:
Pytanie 97
Przeciwwskazaniem do włączenia fingolimodu w leczeniu stwardnienia rozsianego są niżej wymienione, z wyjątkiem:
Pytanie 98
Charakterystyczne dla neuromyelitis optica są:
1) pasmowate zmiany demielinizacyjne w obrębie rdzenia obejmujące co najmniej 3 segmenty;
2) atrofia rdzenia;
3) niecałkowite poprzeczne zapalenia rdzenia;
4) całkowite poprzeczne zapalenie rdzenia;
5) ataksja z oczopląsem.
Prawidłowa odpowiedź to:
Pytanie 99
W leczeniu postaci przerywanej zespołu niespokojnych nóg najlepsze efekty uzyska się po włączeniu:
Pytanie 100
Tętniaki workowate są przyczyną krwotoku podpajęczynówkowego w:
Pytanie 101
Chory lat 75 z chorobą Parkinsona od 8 lat leczony ropinirolem o przedłużonym uwalnianiu w dawce 12 mg rano oraz lewodopą z karbidopą w dawce 4x 250 mg dziennie, ma od 2 tygodni w nocy (niemal codziennie) po przebudzeniu się przywidzenia - widzi nieżyjącego brata, czasem dzieci, z którymi rozmawia - odczuwa w tych sytuacjach nasilony niepokój. W takiej sytuacji należy:
Pytanie 102
U 62-letniej chorej pojawił się nowy ból głowy w okolicy skroniowej lewej, początkowo sporadyczny, o niewielkim nasileniu. Po trzech miesiącach ból stał się codzienny, uporczywy, niereagujący na ogólnie dostępne leki przeciwbólowe. Pojawiło się także ogólne zmęczenie, bóle wielomięśniowe, spadek masy ciała. Dotychczas zdrowa. W badaniu neurologicznym - palpacyjnie niewielka bolesność t. skroniowej lewej, chromanie żuchwy, poza tym bez odchyleń. OB 105 mm/h. Pacjentkę skierowano na biopsję tętnicy skroniowej. Wskaż prawdziwe stwierdzenia:
1) z włączeniem steroidów należy poczekać do wyniku histopatologicznego;
2) należy jak najszybciej włączyć steroidoterapię, ale po pobraniu wycinka tętnicy;
3) można włączyć steroidoterapię, a wykonanie biopsji jest dopuszczalne do dwóch tygodni od początku leczenia;
4) wynik negatywny biopsji wyklucza rozpoznanie olbrzymiokomórkowego zapalenia tętnicy skroniowej;
5) powikłaniem choroby może być ślepota.
Prawidłowa odpowiedź to:
Pytanie 103
Do objawów wykluczających rozpoznanie choroby Parkinsona należy/ą:
Pytanie 104
Do zespołów parkinsonowskich, które przebiegają zazwyczaj bez objawów otępienia należy:
Pytanie 105
Chora lat 55 od 3 lat odczuwała początkowo tylko pieczenie i kłucie pod powiekami, szczególnie po ekspozycji na jasne światło, wiatr, czy obraz telewizyjny. Od roku dochodzi u niej do przymykania powiek, co dodatkowo utrudnia jej codzienne funkcjonowanie. W czasie rozmowy objawy te często się zmniejszają lub niemal ustępują całkowicie. Od pół roku doszło także do ruchów mimowolnych otwierania żuchwy i niemożności utrzymania języka w jamie ustnej. Wskaż najbardziej prawdopodobne rozpoznanie:
Pytanie 106
Do schorzeń przebiegających z gromadzeniem żelaza w jądrach podkorowych należą niżej wymienione, z wyjątkiem:
Pytanie 107
Chory lat 57 z zaburzeniami zasypiania, związanymi z nieprzyjemnym pieczeniem łydek i stóp, które występują niemal codziennie i powodują przewlekłe zmęczenie. Chory ma prawidłową funkcję wątroby, morfologię krwi i poziom cukru. Poziom ferrytyny wynosi 35g/ml. GFR < 35 ml/min/1,73 m2. Skuteczna i bezpieczna terapia możliwa do zastosowania u niego to:
Pytanie 108
W kurczu powiek (blepharospasmus) najskuteczniejszym lekiem pierwszego rzutu jest:
Pytanie 109
Wskaż prawdziwe stwierdzenia dotyczące chirurgicznego leczenia krwotoku śródmózgowego:
1) jest zalecane niezależnie od wielkości i umiejscowienia ogniska krwotocznego;
2) w krwotokach do móżdżku zalecana jest ewakuacja krwi i drenaż komorowy, gdy występują neurologiczne objawy wodogłowia;
3) tromboliza dokomorowa jest zalecana w każdym przypadku krwotoku wewnątrzkomorowego;
4) w krwotokach do móżdżku bezwzględnie konieczna jest ewakuacja krwi i drenaż komorowy gdy ognisko jest większe niż 3 cm;
5) w wodogłowiu niekomunikującym stosuje się drenaż przez dostęp lędźwiowy.
Prawidłowa odpowiedź to:
Pytanie 110
W przypadku pacjenta z wysokim ciśnieniem tętniczym > 220/110 mmHg z udarem niedokrwiennym mózgu, u którego planuje się leczenie trombolityczne:
Pytanie 111
Chory lat 70, obciążony nadciśnieniem tętniczym i hipercholesterolemią - od około roku ma zaburzenia pamięci świeżej. Wcześniej przez rok leczył się z powodu depresji, kilkukrotnie miał też przywidzenia z poczuciem obecności kogoś obcego w mieszkaniu oraz widział małe dzieci. Niekiedy też wydawało mu się, że zamiast żony podstawiono mu inną osobę. Córka chorego zgłaszała, że ojciec miewa jednak „dobre dni”, kiedy zachowuje się „jak dawniej”. Z powodu ww. objawów chory trafił do psychiatry, który włączył mu risperidon w dawce 2 mg dziennie. Po miesiącu omamy ustąpiły, ale chory zaczął się wolniej poruszać, z trudem wstawał z fotela. Najbardziej prawdopodobnym rozpoznaniem jest:
Pytanie 112
Wskaż prawdziwe stwierdzenia dotyczące badania metodą neuroobrazową mózgu u pacjenta z krwotokiem mózgowym:
1) w okresie 0-6 godzin od zachorowania obraz w TK może nie wykazywać „świeżego” ogniska krwotocznego;
2) ognisko krwotoczne w TK ma wzmożoną densyjność (około 40 jH);
3) opcja T* w MR jest sekwencją najszybciej wykazującą „świeży” krwotok śródmózgowy po 24 godz.;
4) zmiana krwotoczna staje się w obrazie TK izodensyjna po 2 dniach od zachorowania.
Prawidłowa odpowiedź to:
Pytanie 113
Na obraz kliniczny PRESS oprócz wzrostu ciśnienia tętniczego składają się najczęściej:
1) zaburzenia oddawania moczu;
2) zaburzenia widzenia (widzenie za mgłą, kwadrantowe ubytki pola widzenia, niedowidzenie połowicze, nawet z ślepotą korową);
3) zmiany krwotoczne w tomografii komputerowej;
4) nudności, wymioty;
5) spowolnienie ruchowe, senność, splątanie, a nawet śpiączka.
Prawidłowa odpowiedź to:
Pytanie 114
Wskaż częste przyczyny krwotoku śródmózgowego:
1) tętniak naczyń wewnątrzczaszkowych;
2) rozwarstwienie tętnic szyjnych;
3) angiopatia amyloidowa;
4) naczyniak tętniczo-żylny;
5) żylna anomalia rozwojowa.
Prawidłowa odpowiedź to:
Pytanie 115
W przypadku udaru niedokrwiennego rdzenia kręgowego prawdą jest, że:
1) udar niedokrwienny rdzenia kręgowego przebiega najczęściej pod postacią zespołu tętnicy rdzeniowej przedniej;
2) udar niedokrwienny rdzenia rozwija się zwykle podostro;
3) badaniem z wyboru w diagnostyce jest TK rdzenia;
4) zniesienie czucia ułożenia jest typowym objawem zespołu tętnicy rdzeniowej przedniej;
5) objawy zespołu tętnicy rdzeniowej tylnej powodują objawy piramidowe.
Prawidłowa odpowiedź to:
Pytanie 116
Wskaż częste lokalizacje tętniaków naczyń mózgowych:
1) tętnica podstawna;
2) tętnica środkowa mózgu;
3) tętnica łącząca tylna;
4) tętnica łącząca przednia;
5) tętnica okołospoidłowa.
Prawidłowa odpowiedź to:
Pytanie 117
Które z poniższych strategii terapeutycznych mają udowodnioną skuteczność w obniżeniu ryzyka zgonu w przypadku udaru spowodowanego krwotokiem śródmózgowym?
1) operacyjne usunięcie ogniska krwotocznego płatowego;
2) dożylne podawanie steroidów;
3) leczenie w pododdziale udarowym;
4) dożylne podawanie rekombinowanego czynnika VII;
5) dożylne podawanie kwasu traneksamowego.
Prawidłowa odpowiedź to:
Pytanie 118
Najwcześniej i najbardziej wiarygodnie ognisko niedokrwienia można stwierdzić w następujących sekwencjach rezonansu magnetycznego:
Pytanie 119
Wskazaniem do stosowania nowych doustnych antykoagulantów jest:
Pytanie 120

